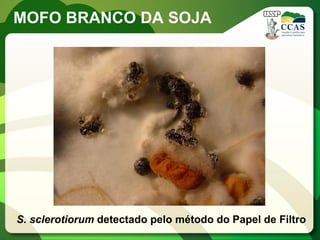
MOFO BRANCO DA SOJA 
S. sclerotiorum detectado pelo método do Papel de Filtro

O documento discute estratégias de manejo para o mofo branco da soja, incluindo fungicidas registrados. Apresenta informações sobre a ocorrência da doença no Brasil e em diferentes culturas, sintomas, ciclo da doença e indicadores para avaliar a eficácia das medidas de controle.